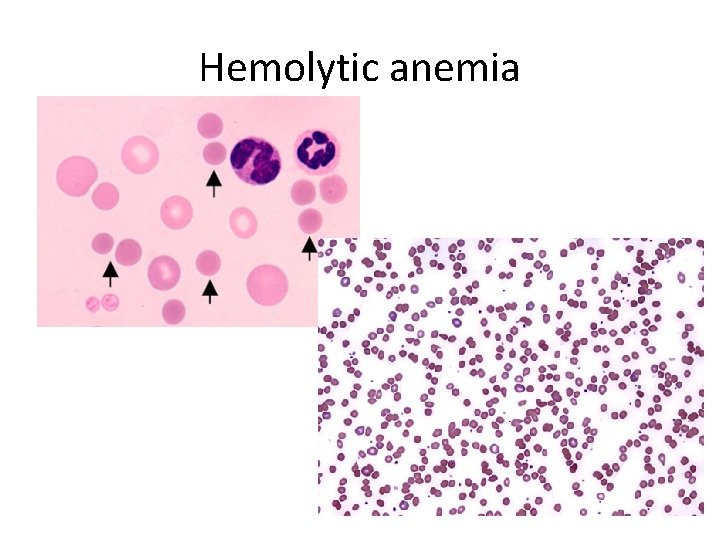
Hemolytic anemia
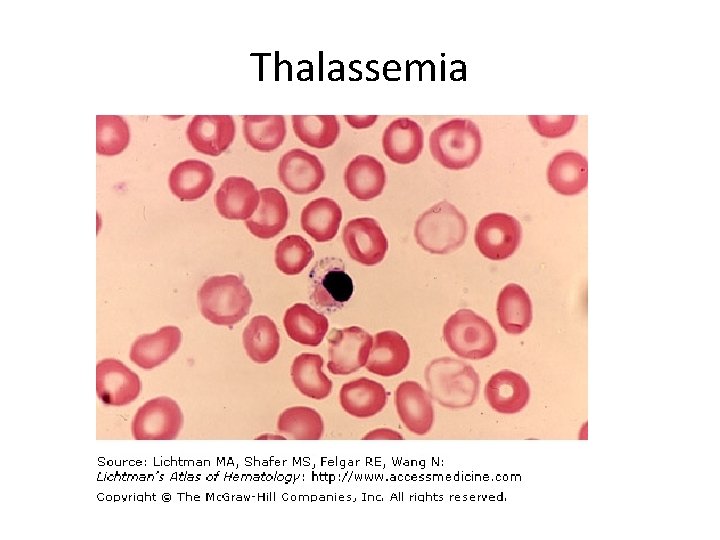
Thalassemia
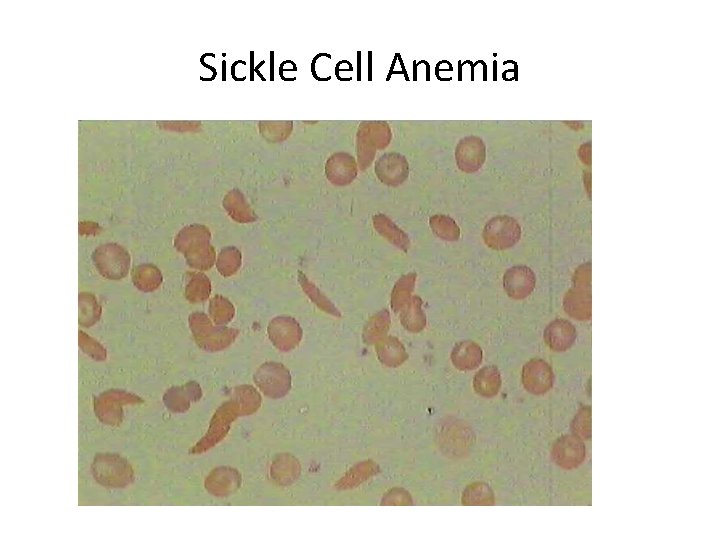
Sickle Cell Anemia

Erythrocyte Disorders Read through these in your notes

- Slides: 16
Erythrocyte Disorders • Read through these in your notes and in your text to make sure you understand the causes and/or symptoms • They will be on your Quiz
Hemolytic anemia
Aplastic Anemia
Thalassemia
Sickle Cell Anemia
Leukocyte Disorders • Read through these in your notes and in your text to make sure you understand the causes and/or symptoms • They will be on your Quiz
Disorders of Hemostasis • Type I: Thromboembolytic conditions – undesirable clot formation – Thrombus: clot that develops in an unbroken blood vessel – Embolus: thrombus that breaks away from BV wall and floats freely in bloodstream • Either may block circulation to tissues beyond the occlusion and cause death to those tissues • Pulmonary embolism, stroke, heart attack
Disorders of Hemostasis • Endothelial roughening: impairment of endothelial characteristics such as arteriosclerosis, severe burns/scar tissue, or inflammation may give platelets a place to cling and begin a thrombus • Blood stasis: slowing of blood flow particularly in immobilized patients does not keep clotting factors diluted
Disorders of Hemostasis • Bleeding disorders: prevention of proper clot formation – Thrombocytopenia: platelet count under 50, 000 per mm 3 • Petechiae: small purplish blotches (bruises) caused by spontaneous bleeding from small BV all over body • Cause: damage to myeloid tissue (bone marrow): bone marrow cancer, radiation, certain drugs • Treatment: whole blood transfusion or in some cases platelet transfusion
Disorders of Hemostasis • Impaired liver function – Little to no procoagulants produced – Causes: vitamin K deficiency, hepatitis, cirrhosis • Vitamin K is a fat soluble vitamin produced in your intestines by bacteria: liver produces bile which is necessary for fat absorption – No bile = no fat absorption = vitamin K deficiency = no procoagulant production – Treatment: Depends on cause
Hemophilia: What is it? • Hereditary X linked trait so usually affects males – Hemophilia A = factor VIII deficiency – most common – Hemophilia B – factor IX deficiency – Hemophilia C – factor XI deficiency • Symptoms: minor tissue trauma causes prolonged bleeding, bleeding into joint capsules after exercise or trauma • Management: clotting factor transfusion
Developmental Aspects • Embryonic – Day 28 of pregnancy – RBC in fetal circulation – By 7 th month: red marrow is chief site of hematopoiesis – Hb. F – fetal hemoglobin • Greater ability to pick up oxygen • Replaced by Hb. A after birth • Immature liver may lead to physiological jaundice since bilirubin is not excreted
Developmental Aspects • Adulthood – Dietary deficiencies or metabolic disorders cause abnormalities in BC formation or hemoglobin production – Iron deficient anemia more common in women
Developmental Aspects • Old age – Leukemia risk – Pernicious anemia • Stomach mucosa atrophies with age • Less intrinsic factor (located in lining of stomach – function is B 12 absorption) • Less B 12 absorption • Leads to pernicious anemia
Diagnostic Blood Tests • • • low hematocrit = anemia high fat level (lipidemia) = problems with heart disease blood glucose test – diabetes, hypoglycemia, hyperglycemia differential WBC indicates type of infection platelet count – thrombocytopenia – clotting problems complete blood count = CBC – – includes all aspects of blood – typically done to eliminate possibilities or give doctors a direction to go